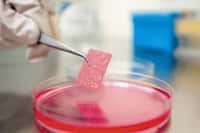

Kreuzbandriss und Knorpelschaden im Kniegelenk: Für viele Athleten bedeutete das in der Vergangenheit das Karriereaus. Heute setzen moderne Mediziner verletzten Sportlern ein neues Kreuzband ein und füllen Löcher auf den Gelenken mit körpereigenen Knorpelzellen. Hinterher ist es den meisten möglich, ihr altes Sportlerleben wieder aufzunehmen.
Orthopäde und Unfallchirurg Dr. Johannes Holz aus Hamburg (www.luetten-holz.de, www.park-klinik-manhagen.de) hat uns einige seiner OP-Videos zur Verfügung gestellt, um heutige, modernste arthroskopische Operationstechniken anschaulich darzustellen.
Knorpelschaden
Bei dieser Sportverletzung handelt es sich um einen viertgradigen Knorpelschaden. Zu der Daumennagel großen Abtragung des Knorpels kommt noch ein Kreuzbandriss.
Video:
Dr. Johannes Holz
3 Monate nach der OP
Das Trägervlies mit der Kultur von Knorpelzellen ist auf der verletzen Stelle aufgewachsen. Das Trägermaterial hat bereits begonnen, sich aufzulösen. Die neue Knorpelschicht hat noch nicht ihre volle Stärke erreicht. Dafür braucht es noch etwa sechs bis neun Monate.
Video:
Dr. Johannes Holz
OP am offenen Knie
Während der Chirug bei der Arthroskopie das Kniegelenk durch ein Loch in Haut und Gewebe erreicht, wird bei der offenen Operation das Kniegelenk fast komplett freigelegt.
Transplantation
Für die Zell-Transplantation wurden vorher extra körpereigene Knorpelzellen vermehrt und auf ein Vlies aufgetragen. Dieses wird nun vorsichtig und zurechtgeschnitten auf die entblößte Stelle des Knochens aufgetragen.
Video:
Dr. Johannes Holz
Unebene Knorpel
Unebenheiten auf dem Knorpel verursachen beim Betreffenden ziemlich große Schmerzen. Deshalb werden sie – falls die Substanz es zulässt – quasi einfach "weggehobelt". Dabei glättet der Chirurg den Knorpel mit einem hobelartigen Messer, bis die Gelenkflächen wieder einwandfrei übereinander gleiten.
Video:
Dr. Johannes Holz
Knorpel durch Stammzellen
Eine weitere Methode, um bei schweren (viertgradigen) Schäden neue Knorpelmasse aufzubauen, nutzt die extreme Wandlungsfähigkeit von Stammzellen. Dafür schlägt der Chirurg zahlreiche, etwa 5 Millimeter tiefe Löcher in den Knochen.
Video:
Dr. Johannes Holz
Bluten ist nützlich
Nachdem der Chirurg Löcher (Mikrofrakturen) in den Knochen geschlagen hat, beginnt die Blutung. Daraus entsteht später ungeordnete Knorpelmasse, so genannter Faserknorpel.